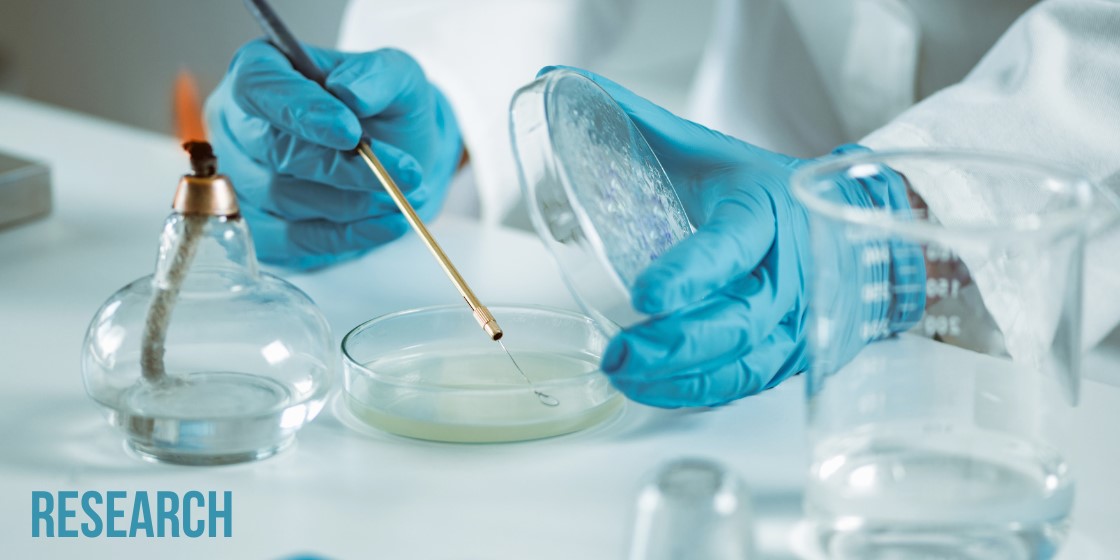

Biomedical Health Sciences
The Department of Biomedical Health Sciences is a multidisciplinary department offering a variety of courses concerning those sciences related to the human body; for example, anatomy and physiology and microbiology. The department is located in Lamb Hall, shown on this map and world view.
The department offers the B.S. degree in Health Sciences, the B.S. degree in Health
Sciences with a concentration in Biomedical Sciences, and the B.S. degree in Microbiology.
In addition, minors in Health Sciences and Microbiology are offered. An M.S. degree
in Biological Sciences with a concentration in Microbiology or a concentration in
Biomedical Sciences is available to graduate students. Our degree programs offer
excellent preparation for medical, dental, physician assistant, pharmacy, public health,
therapy, and other professional and graduate school programs.
According to Dean Randy Wykoff, “There are many outstanding majors at ETSU that prepare students for entry into graduate and professional schools, including those related to careers in the health professions. I am particularly proud of the remarkable success of the graduates from our Health Science program. Their faculty have prepared them exceptionally well, both in the classroom and in the laboratory.”
Top 10 Biotech Jobs Most in Demand through 2024
Stout Drive Road Closure